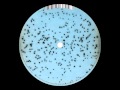

Running Back
12 avril 2011
Allemagne
Statut
Nouveau
Disponibilité
Prévu le
Prix
18,39 €
Disponibilité
Prévu le
Détails
| Titre | Colliding Stars Pt.2 |
| Artiste | Marco Passarani |
| Format | LP (e) |
| Maisons d'édition | Running Back |
| Pays d'édition | Allemagne |
| Date de sortie | 12 avril 2011 |
| Première mise sur le marché | 2011 |
| Poids | 230 g |
| EAN | 0827170362567 |
| Identifiant du produit | 902504 |
| ID Discogs | 2729025 |
| Critiques Discogs |
4.24
|
Marco Passarani
Notre avis :
FR Livraison dès 9,56 €
Vous trouverez ici Tous les!
Via
209 000
Disquer 33 tours et les
378 000
CD
en offre
Remise de fidélité jusqu'à 5%
Pour les clients enregistrés
Garder la vue d'ensemble!
Le suivi le plus avancé
de la disponibilité et des commandes